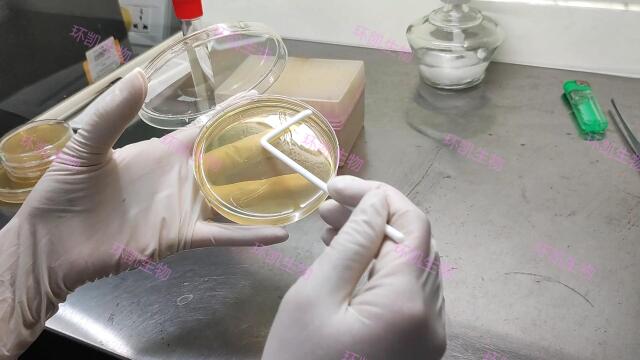
90mm平皿培养涂布接种操作介绍
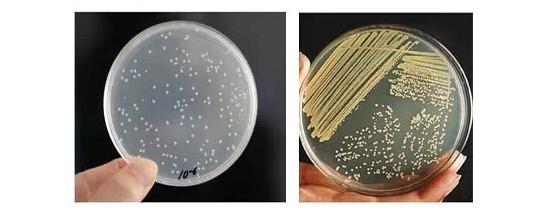
涂布平板法

平板涂布

涂布平板后产生的菌落
图片尺寸1024x768
90mm平皿培养涂布接种操作介绍
图片尺寸640x360
微生物实验-涂布平板
图片尺寸1728x1080
pct与pet32a连接产物的平板涂布
图片尺寸1080x1439
07.平板涂布操作_哔哩哔哩_bilibili
图片尺寸1440x900
平板涂布法菌落总数 - 食品 - 水产品,畜产品 - 小木虫论坛-学术科研
图片尺寸675x900
涂布平板法
图片尺寸545x211
比克曼生物(bkmam)电动平板涂布器手动微生物培养基涂抹器培养平板涂
图片尺寸800x800
稀释涂布平板法计数公式
图片尺寸793x414
第七章 微生物的生长及其控制_word文档在线阅读与下载_无忧文档
图片尺寸562x510
大肠杆菌稀释涂布平板法 - 微生物 - 培养/筛选 - 小木虫论坛-学术科
图片尺寸828x828
几种常见的微生物接种方法介绍及其优缺点比较!-环凯培养基生产,细胞
图片尺寸532x345
微生物平板涂布法求助!! - 知乎
图片尺寸2560x1920
平板划线法为什么不能计数,稀释涂布平板法为什么可以计数和纯化.
图片尺寸534x300
300克 防水哑光白底纯棉油画布-江苏浙创纺织科技有限公司
图片尺寸1920x690
【厂家直销 全棉平纹布涂层 涂层布 黑色涂层布 服装面料羽绒服面料】
图片尺寸1920x1280
涂布法菌落计数问题 - 微生物 - 培养/筛选 - 小木虫论坛-学术科研互
图片尺寸900x675
用实践的精神,探寻微观世界的奥秘.——2019莆田市初中生物实验技能培
图片尺寸2666x2000
微生物平板涂布法求助!! - 知乎
图片尺寸1920x2560
高中生物实验课 | 稀释涂布平板法 | 微生物 🥰上周带同学们在实验
图片尺寸960x1280